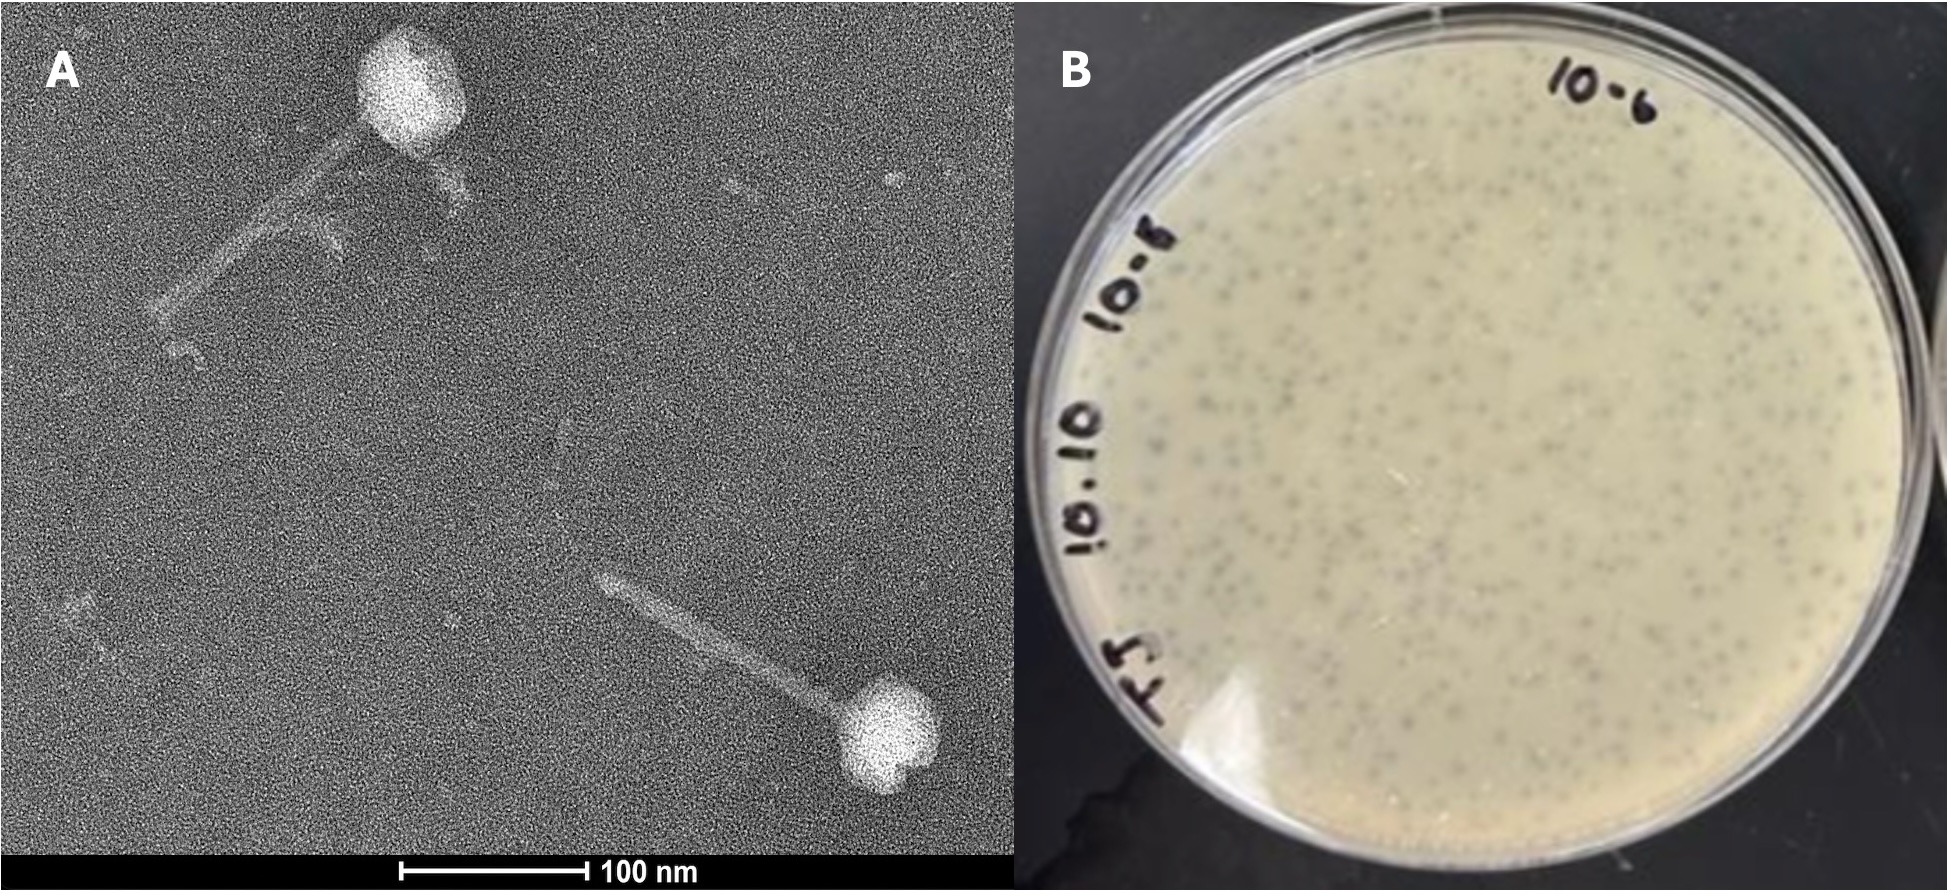

Arib Ahsan1*, Ruby S Crosthwait1*, Josephine J Crosthwait1*, Srilekha Davuluri2*, Omoye N Ehimare1*, Yihao Fan1*, Tiarra Nikitha Joseph Philomen Raju3*, Jamie Kim1*, Alexander Y Lee1*, Nicholas K Odani3*, Mugil V Shanmugam3*, Anmol Singhal3*, Alana J Snyder1,4*, Jessica W Sy5*, Grace Y Wang1*, George W Zhou1*, and Christa T Bancroft1§*
1Department of Biological Sciences, University of Southern California, Los Angeles, California, United States
2Department of Sociology, University of Southern California, Los Angeles, California, United States
3Department of Quantitative and Computational Biology, University of Southern California, Los Angeles, California, United States
4Department of Chemistry, University of Southern California, Los Angeles, California, United States
5Department of Gerontology, University of Southern California, Los Angeles, California, United States
§Correspondence to: Christa T Bancroft (cbancrof@usc.edu)
* Authors have equal contribution
Abstract
Figure 1.
Figure 1.Description
Acknowledgements
Funding
Author Contributions
- Arib Ahsan: Data curation, Formal analysis, Investigation, Validation, Writing - original draft
- Ruby S Crosthwait: Data curation, Formal analysis, Investigation, Validation, Writing - original draft
- Josephine J Crosthwait: Data curation, Formal analysis, Investigation, Validation, Writing - original draft
- Srilekha Davuluri: Data curation, Formal analysis, Investigation, Supervision, Software, Validation, Writing - original draft
- Omoye N Ehimare: Data curation, Formal analysis, Investigation, Validation, Writing - original draft
- Yihao Fan: Data curation, Formal analysis, Investigation, Validation, Writing - original draft
- Tiarra Nikitha Joseph Philomen Raju: Data curation, Formal analysis, Investigation, Validation, Writing - original draft
- Jamie Kim: Data curation, Formal analysis, Investigation, Validation, Writing - original draft
- Alexander Y Lee: Data curation, Formal analysis, Investigation, Validation, Writing - original draft
- Nicholas K Odani: Data curation, Investigation, Validation, Writing - original draft, Formal analysis
- Mugil V Shanmugam: Data curation, Formal analysis, Investigation, Validation, Writing - original draft
- Anmol Singhal: Data curation, Formal analysis, Investigation, Validation, Writing - original draft
- Alana J Snyder: Data curation, Investigation, Validation, Writing - original draft, Formal analysis
- Jessica W Sy: Investigation, Data curation, Validation, Writing - original draft, Formal analysis
- Grace Y Wang: Investigation, Data curation, Formal analysis, Validation, Writing - original draft
- George W Zhou: Data curation, Formal analysis, Validation, Writing - original draft, Investigation
- Christa T Bancroft: Data curation, Formal analysis, Project administration, Supervision, Writing - review & editing, Writing - original draft
Reviewed By
Anonymous
History
- Received: 9/13/2024
- Revision Received: 11/7/2024
- Accepted: 11/7/2024
- Published Online: 11/7/2024
- Indexed: 11/21/2024
Copyright
© 2024 by the authors. This is an open-access article distributed under the terms of the Creative Commons Attribution 4.0 International (CC BY 4.0) License, which permits unrestricted use, distribution, and reproduction in any medium, provided the original author and source are credited.
Citation
PubMed Central: 11582879
PubMed: 39583577

